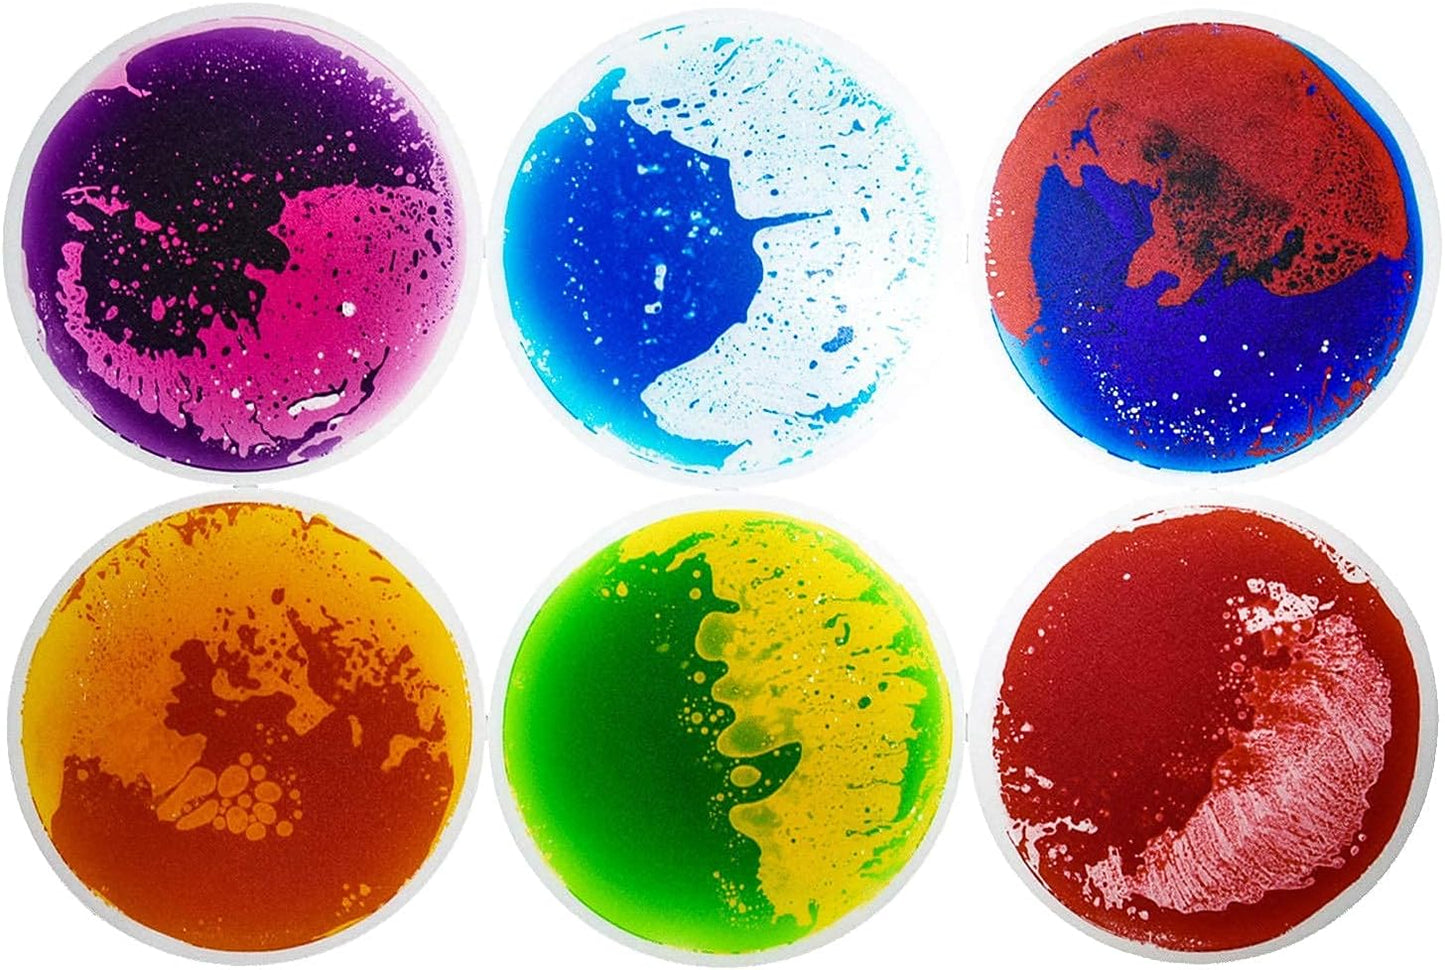

Art3d 圓形液體感統地墊 50cm直徑六片裝 Art3d Round Liquid Tiles 19.7" Diameter 6-Pack
Art3d 圓形液體感統地墊 50cm直徑六片裝 Art3d Round Liquid Tiles 19.7" Diameter 6-Pack
Couldn't load pickup availability
🌈 Art3d 圓形液體感統地墊|50cm直徑六片裝
🎨 360°動態色彩互動|居家遊樂新體驗
🟢 圓形液體魔法
• 6片直徑50cm圓形地墊
• 踩踏時液體呈現漩渦流動效果
• 醫療級無毒密封液體
⚙️ 創新安全設計
✓ 環形防滑底紋,360°防護
✓ 加厚透明上層,耐刮抗壓
✓ 獨特圓邊防漏技術
🔄 趣味互動玩法
• 旋轉跳舞遊戲 • 顏色追逐賽
• 平衡感訓練 • 團體互動活動
🏡 空間美化應用
✔️ 兒童遊戲區 ✔️ 感統教室
✔️ 親子館 ✔️ 咖啡廳兒童角
🧽 智能維護
• 食品級可水洗表面
• 圓形疊收省空間
• 快速拆裝移動
讓每個轉身都綻放彩色漣漪!
🌈 Art3d Round Liquid Tiles|19.7" Diameter 6-Pack
🎨 360° Color Vortex|Next-Gen Play
🟢 Liquid Vortex Effect
• 6 round tiles (19.7" diameter)
• Swirling liquid motion when stepped on
• Medical-grade non-toxic fluid
⚙️ Safety Innovation
✓ 360° non-slip ring base
✓ Scratch-resistant thick surface
✓ Unique circular sealing tech
🔄 Interactive Play
• Spin dance challenges • Color chase games
• Balance training • Group activities
🏡 Space Transformation
✔️ Play zones ✔️ Therapy rooms
✔️ Family cafes ✔️ Retail displays
🧽 Smart Maintenance
• Food-grade washable surface
• Space-saving circular stacking
• Quick relocation
Where every turn creates ripples of joy!
Share